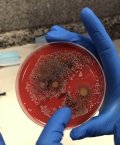

Guerres chimique et biologique

La communauté internationale a pris conscience de la nécessité d’interdire l’emploi des armes chimiques et biologiques après la Première Guerre mondiale. Cette interdiction fut renforcée en 1972 et 1993, prohibant la mise au point, la production, le stockage et le transfert de ce type d’armes. Mais les programmes militaires, bénéficiant des avancées dans les domaines des sciences de la vie et de la biotechnologie, et se finançant sur des fonds secrets, ont été poursuivis par des grandes puissances.
© Geopolintel 2009-2026 -
site réalisé avec SPIP -
l'actualité Geopolintel avec RSS